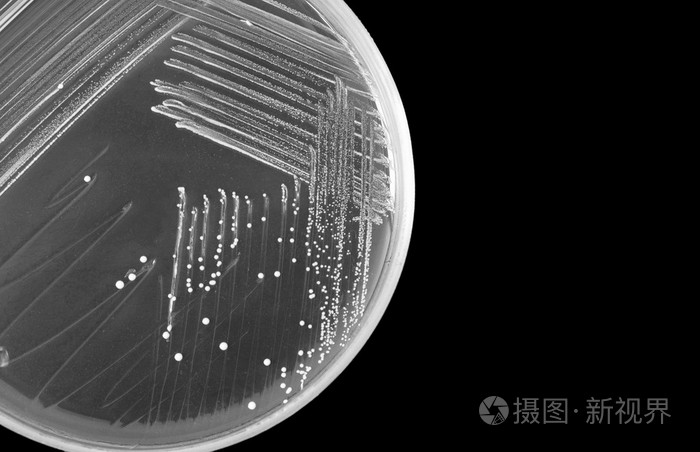
细菌培养皿上黑色背景孤立的宏

培养皿细菌图片

在培养皿里繁殖的下水道肠杆菌.cdc
图片尺寸623x480
培养皿上的细菌菌落
图片尺寸1162x1100
在黑色背景下分离的培养皿上的不同细菌菌落照片
图片尺寸317x300
有霉菌的培养皿
图片尺寸1100x1100
贝兰伯细菌培养皿.bioland 细菌培养皿bcd06系列 - 抖音
图片尺寸1333x750
培养皿里的超大病菌图片
图片尺寸1000x1000
用豆腐甘蔗煮壶,反而让壶成了细菌培养皿
图片尺寸1146x1136
大家帮我看看培养皿是什么菌啊
图片尺寸2560x1920
biosharp bs-90-d 90mm一次性塑料微生物培养皿细菌培养皿10个/包
图片尺寸800x800
生物专家用培养皿画画,画成的细菌作品,色彩炸裂
图片尺寸1000x1000
越来越多的病毒和细菌细胞的培养皿.微生物
图片尺寸1024x713
细菌培养皿上黑色背景孤立的宏
图片尺寸700x452
培养皿细菌培养
图片尺寸700x489
实验室显微镜和培养皿与细菌显微镜下细菌培养的分析显微镜下细菌的
图片尺寸700x467
培养皿中生长的细菌照片
图片尺寸300x300
有霉菌的培养皿
图片尺寸1100x1100
有盖培养皿中的细菌培养
图片尺寸1200x800
给位大侠,麻烦帮忙看看培养皿上的什么菌,最近做菌落经常出现这样的
图片尺寸3264x2448
不同的细菌和霉菌菌落生长在有营养琼脂的培养皿上
图片尺寸1200x795
培养皿染菌是什么情况?分别有什么样的对策?_包装_细菌_培养基
图片尺寸798x542